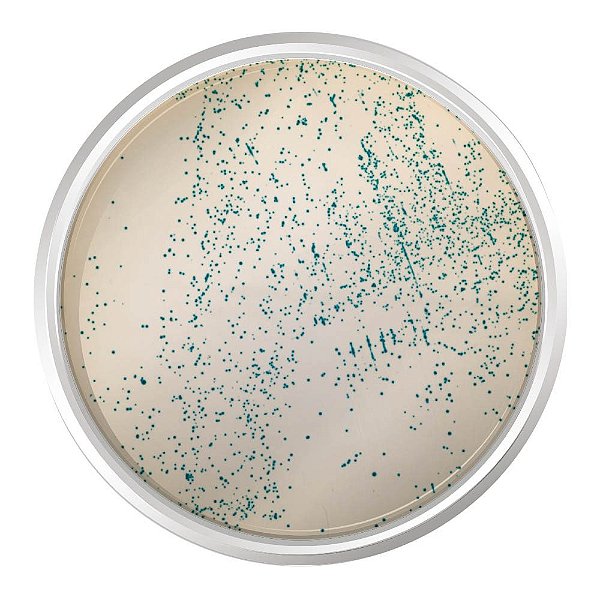
AGAR CROMOGENICO M-EI BASE 500G - KASVI

AGAR CROMOGENICO M-EI BASE 500G - KASVI
Agar Cromogênico m-EI Base 500g – Kasvi K25-1412
Produtos relacionados
-
 AGAR CROMOGENICO SALMONELLA 500G - KASVIR$ 3.739,28até 6x de R$ 623,21 sem jurosou R$ 3.664,49 via Pix
AGAR CROMOGENICO SALMONELLA 500G - KASVIR$ 3.739,28até 6x de R$ 623,21 sem jurosou R$ 3.664,49 via Pix -
 AGAR CROMOGENICO CANDIDA PLUS 500G - KASVIR$ 2.733,15até 6x de R$ 455,52 sem jurosou R$ 2.678,49 via Pix
AGAR CROMOGENICO CANDIDA PLUS 500G - KASVIR$ 2.733,15até 6x de R$ 455,52 sem jurosou R$ 2.678,49 via Pix -
 AGAR CROMOGENICO LISTERIA BASE (ISO 11290-1) 500G - KASVIR$ 1.372,70até 6x de R$ 228,78 sem jurosou R$ 1.345,25 via Pix
AGAR CROMOGENICO LISTERIA BASE (ISO 11290-1) 500G - KASVIR$ 1.372,70até 6x de R$ 228,78 sem jurosou R$ 1.345,25 via Pix -
 AGAR CROMOGENICO E.COLI COLIFORMES (CCA) ISO 9308-1 500G - KASVIR$ 5.223,84até 6x de R$ 870,64 sem jurosou R$ 5.119,36 via Pix
AGAR CROMOGENICO E.COLI COLIFORMES (CCA) ISO 9308-1 500G - KASVIR$ 5.223,84até 6x de R$ 870,64 sem jurosou R$ 5.119,36 via Pix
-
A Lab-Bran atua há mais de 20 anos entregando insumos com precisão, responsabilidade e documentação correta pra quem não pode errar no laboratório. Atendemos hospitais, clínicas médicas e veterinárias, universidades, laboratórios de análises, indústrias e agronegócio — com estoque técnico e emissão fiscal pronta pra cada tipo de cliente. Seja qual for sua área, se você precisa de insumos confiáveis, pode contar com a Lab-Bran.